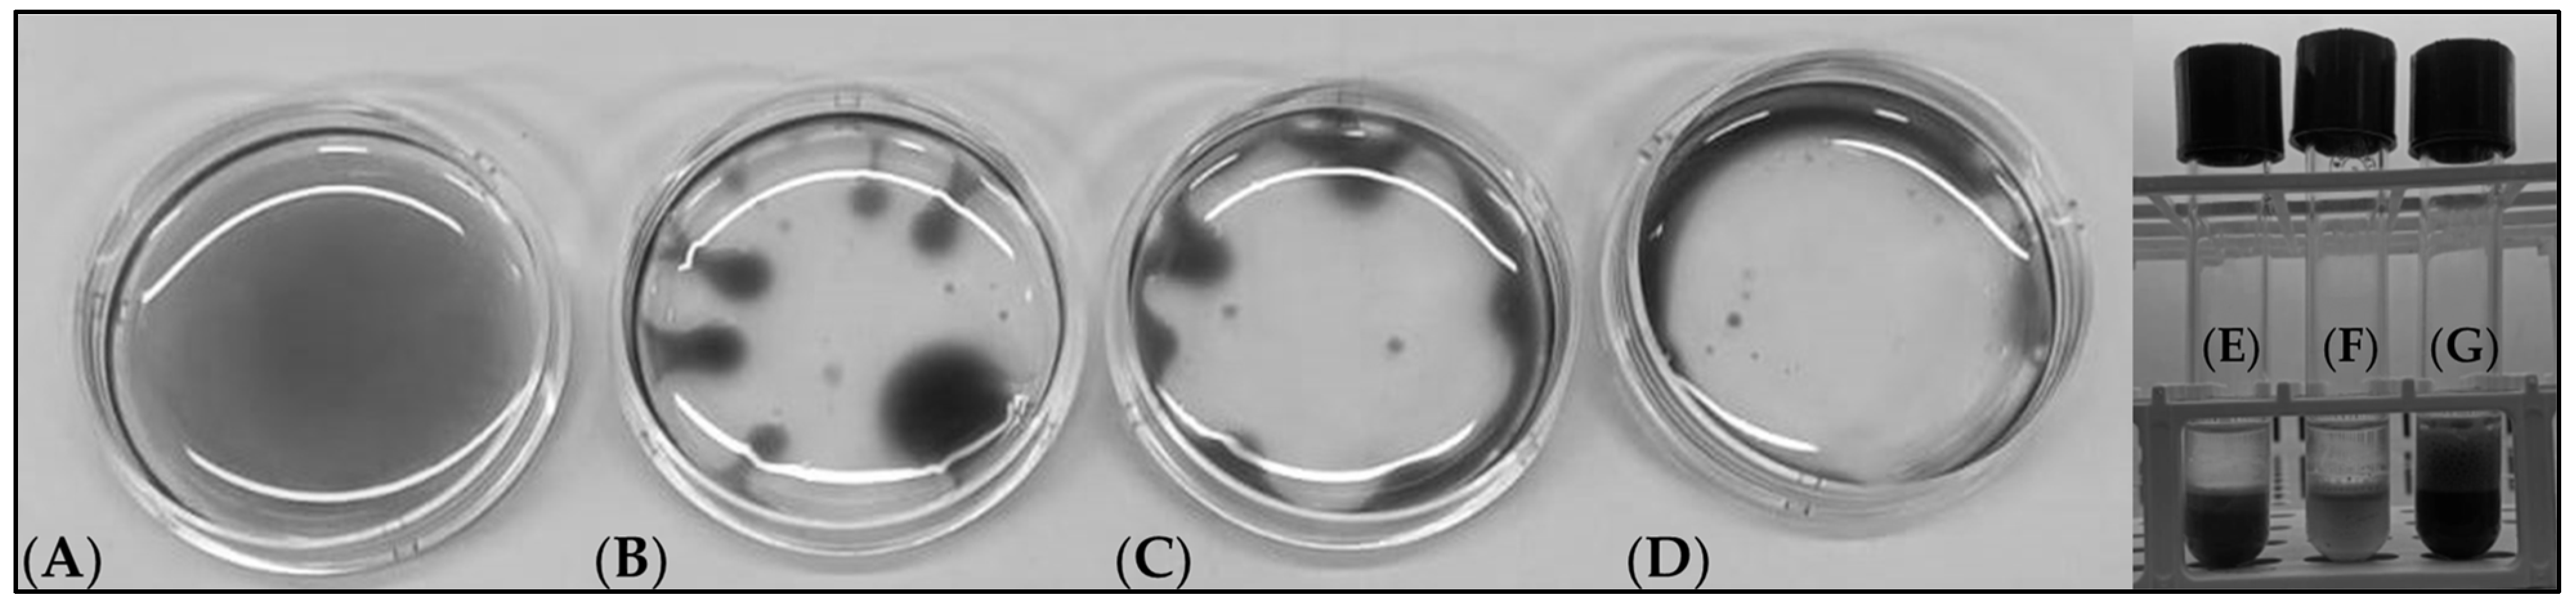
Fermentation 11 00074 g001

Identification of Corn Chaff as an Optimal Substrate for the Production of Rhamnolipids in Pseudomonas aeruginosa Fermentations
Abstract
1. Introduction
2. Materials and Methods
2.1. Microbial Strains, Culture Media, and Culture Conditions
2.2. Analytical Methods
2.2.1. Acid Hydrolysis and HPLC Quantification of Rhamnolipids and Sophorolipids (Glycolipids)
2.2.2. LC-MS Analysis of Rhamnolipids
2.2.3. HPLC Analysis of Surfactin
2.3. Oil Displacement Test (ODA)
2.4. Emulsification Index (EI24(%))
2.5. Qualitative Analysis of the Biosurfactants by Thin-Layer Chromatography (TLC)
2.6. pH Analysis
2.7. Microscopic and Macroscopic Monitoring
2.8. Extraction of Rhamnolipids from Fermentation Broths
3. Results
3.1. Chemical Composition of the Agro-Wastes
3.2. Testing of Agricultural Waste as the Growth Substrate for Target Biosurfactant Producing Microorganisms
3.3. Production of Biosurfactants from Microbial Strains Grown on Agro-Wastes
3.4. Formulation of a Suitable Fermentation Medium Based on Corn Chaff for the Production of Rhamnolipids
3.5. Evaluation of the Optimal Corn Chaff Concentration and of the Effect of α-Amylase on Rhamnolipid Production
3.6. Study of the Fermentation of P. aeruginosa in Medium BCS388
3.7. Purification of Rhamnolipids from Medium BCS388 and Identification of the Different Congeners
4. Discussion
5. Conclusions
Supplementary Materials
Author Contributions
Funding
Institutional Review Board Statement
Informed Consent Statement
Data Availability Statement
Acknowledgments
Conflicts of Interest
References
- Vandamme, E.J. Agro-Industrial Residue Utilization for Industrial Biotechnology Products. In Biotechnology for Agro-Industrial Residues Utilisation: Utilisation of Agro-Residues; Springer: Berlin/Heidelberg, Germany, 2009. [Google Scholar]
- Belc, N.; Mustatea, G.; Apostol, L.; Iorga, S.; Vlǎduţ, V.N.; Mosoiu, C. Cereal Supply Chain Waste in the Context of Circular Economy. E3S Web Conf. 2019, 112, 03031. [Google Scholar] [CrossRef]
- Schäfer, A. Hemicellulose-Degrading Bacteria and Yeasts from the Termite Gut. J. Appl. Bacteriol. 1996, 80, 471–478. [Google Scholar] [CrossRef]
- Sadh, P.K.; Duhan, S.; Duhan, J.S. Agro-Industrial Wastes and Their Utilization Using Solid State Fermentation: A Review. Bioresour. Bioprocess. 2018, 5, 1. [Google Scholar] [CrossRef]
- Astudillo, Á.; Rubilar, O.; Briceño, G.; Diez, M.C.; Schalchli, H. Advances in Agroindustrial Waste as a Substrate for Obtaining Eco-Friendly Microbial Products. Sustainability 2023, 15, 3467. [Google Scholar] [CrossRef]
- Nunes, H.M.A.R.; Vieira, I.M.M.; Santos, B.L.P.; Silva, D.P.; Ruzene, D.S. Biosurfactants Produced from Corncob: A Bibliometric Perspective of a Renewable and Promising Substrate. Prep. Biochem. Biotechnol. 2022, 52, 123–134. [Google Scholar] [CrossRef]
- Awogbemi, O.; Kallon, D.V. Von Pretreatment Techniques for Agricultural Waste. Case Stud. Chem. Environ. Eng. 2022, 6, 100229. [Google Scholar] [CrossRef]
- Chen, J.; Ma, X.; Liang, M.; Guo, Z.; Cai, Y.; Zhu, C.; Wang, Z.; Wang, S.; Xu, J.; Ying, H. Physical–Chemical–Biological Pretreatment for Biomass Degradation and Industrial Applications: A Review. Waste 2024, 2, 451–473. [Google Scholar] [CrossRef]
- Ferdeș, M.; Dincă, M.N.; Moiceanu, G.; Zăbavă, B.Ș.; Paraschiv, G. Microorganisms and Enzymes Used in the Biological Pretreatment of the Substrate to Enhance Biogas Production: A Review. Sustainability 2020, 12, 7205. [Google Scholar] [CrossRef]
- Ravindran, R.; Hassan, S.S.; Williams, G.A.; Jaiswal, A.K. A Review on Bioconversion of Agro-Industrial Wastes to Industrially Important Enzymes. Bioengineering 2018, 5, 93. [Google Scholar] [CrossRef]
- Matei, J.C.; Oliveira, J.A.D.S.; Pamphile, J.A.; Polonio, J.C. Agro-Industrial Wastes for Biotechnological Production as Potential Substrates to Obtain Fungal Enzymes. Ciência Nat. 2021, 43, e72. [Google Scholar] [CrossRef]
- Santos, B.L.P.; Jesus, M.S.; Mata, F.; Prado, A.A.O.S.; Vieira, I.M.M.; Ramos, L.C.; López, J.A.; Vaz-Velho, M.; Ruzene, D.S.; Silva, D.P. Use of Agro-Industrial Waste for Biosurfactant Production: A Comparative Study of Hemicellulosic Liquors from Corncobs and Sunflower Stalks. Sustainability 2023, 15, 6341. [Google Scholar] [CrossRef]
- Sundaram, T.; Govindarajan, R.K.; Vinayagam, S.; Krishnan, V.; Nagarajan, S.; Gnanasekaran, G.R.; Baek, K.H.; Rajamani Sekar, S.K. Advancements in Biosurfactant Production Using Agro-Industrial Waste for Industrial and Environmental Applications. Front. Microbiol. 2024, 15, 1357302. [Google Scholar] [CrossRef]
- Nogueira, I.B.; Rodríguez, D.M.; Da Silva Andradade, R.F.; Lins, A.B.; Bione, A.P.; Da Silva, I.G.S.; Franco, L.D.O.; De Campos-Takaki, G.M. Bioconversion of Agroindustrial Waste in the Production of Bioemulsifier by Stenotrophomonas maltophilia UCP 1601 and Application in Bioremediation Process. Int. J. Chem. Eng. 2020, 2020, 9434059. [Google Scholar] [CrossRef]
- Desai, J.D.; Banat, I.M. Microbial Production of Surfactants and Their Commercial Potential. Microbiol. Mol. Biol. Rev. 1997, 61, 47–64. [Google Scholar] [CrossRef]
- Uzoigwe, C.; Burgess, J.G.; Ennis, C.J.; Rahman, P.K.S.M. Bioemulsifiers Are Not Biosurfactants and Require Different Screening Approaches. Front. Microbiol. 2015, 6, 245. [Google Scholar] [CrossRef] [PubMed]
- Zajic, J.E.; Guignard, H.; Gerson, D.F. Properties and Biodegradation of a Bioemulsifier from Corynebacterium hydrocarboclastus. Biotechnol. Bioeng. 1977, 19, 1303–1320. [Google Scholar] [CrossRef]
- Zhang, Y.; Miller, R.M. Enhanced Octadecane Dispersion and Biodegradation by a Pseudomonas Rhamnolipid Surfactant (Biosurfactant). Appl. Env. Microbiol. 1992, 58, 3276–3282. [Google Scholar] [CrossRef] [PubMed]
- Alizadeh-Sani, M.; Hamishehkar, H.; Khezerlou, A.; Azizi-Lalabadi, M.; Azadi, Y.; Nattagh-Eshtivani, E.; Fasihi, M.; Ghavami, A.; Aynehchi, A.; Ehsani, A. Bioemulsifiers Derived from Microorganisms: Applications in the Drug and Food Industry. Adv. Pharm. Bull. 2018, 8, 191–199. [Google Scholar] [CrossRef] [PubMed]
- Mgbechidinma, C.L.; Akan, O.D.; Zhang, C.; Huang, M.; Linus, N.; Zhu, H.; Wakil, S.M. Integration of Green Economy Concepts for Sustainable Biosurfactant Production—A Review. Bioresour. Technol. 2022, 364, 128021. [Google Scholar] [CrossRef]
- Shekhar, S.; Sundaramanickam, A.; Balasubramanian, T. Biosurfactant Producing Microbes and Their Potential Applications: A Review. Crit. Rev. Env. Sci. Technol. 2015, 45, 1522–1554. [Google Scholar] [CrossRef]
- Henkel, M.; Hausmann, R. Diversity and Classification of Microbial Surfactants. In Biobased Surfactants: Synthesis, Properties, and Applications; AOCS Press: Washington, DC, USA, 2019. [Google Scholar]
- Santos, D.K.F.; Rufino, R.D.; Luna, J.M.; Santos, V.A.; Sarubbo, L.A. Biosurfactants: Multifunctional Biomolecules of the 21st Century. Int. J. Mol. Sci. 2016, 17, 401. [Google Scholar] [CrossRef]
- Eslami, P.; Hajfarajollah, H.; Bazsefidpar, S. Recent Advancements in the Production of Rhamnolipid Biosurfactants By Pseudomonas aeruginosa. RSC Adv. 2020, 10, 34014–34032. [Google Scholar] [CrossRef] [PubMed]
- Chen, J.; Wu, Q.; Hua, Y.; Chen, J.; Zhang, H.; Wang, H. Potential Applications of Biosurfactant Rhamnolipids in Agriculture and Biomedicine. Appl. Microbiol. Biotechnol. 2017, 101, 8309–8319. [Google Scholar] [CrossRef] [PubMed]
- Abdel-Mawgoud, A.M.; Hausmann, R.; Lépine, F.; Müller, M.M.; Déziel, E. Rhamnolipids: Detection, Analysis, Biosynthesis, Genetic Regulation, and Bioengineering of Production. Biosurfactants Genes Appl. 2011, 20, 13–55. [Google Scholar]
- Chong, H.; Li, Q. Microbial Production of Rhamnolipids: Opportunities, Challenges and Strategies. Microb. Cell Fact. 2017, 16, 137. [Google Scholar] [CrossRef]
- Wittgens, A.; Rosenau, F. Heterologous Rhamnolipid Biosynthesis: Advantages, Challenges, and the Opportunity to Produce Tailor-Made Rhamnolipids. Front. Bioeng. Biotechnol. 2020, 8, 594010. [Google Scholar] [CrossRef] [PubMed]
- Naughton, P.J.; Marchant, R.; Naughton, V.; Banat, I.M. Microbial Biosurfactants: Current Trends and Applications in Agricultural and Biomedical Industries. J. Appl. Microbiol. 2019, 127, 12–28. [Google Scholar] [CrossRef]
- Soberón-Chávez, G.; González-Valdez, A.; Soto-Aceves, M.P.; Cocotl-Yañez, M. Rhamnolipids Produced by Pseudomonas: From Molecular Genetics to the Market. Microb. Biotechnol. 2021, 14, 136–146. [Google Scholar] [CrossRef]
- Shaligram, N.S.; Singhal, R.S. Surfactin—A Review on Biosynthesis, Fermentation, Purification and Applications. Food Technol. Biotechnol. 2010, 48, 119–134. [Google Scholar]
- D’Almeida, A.P.; de Albuquerque, T.L.; Rocha, M.V.P. Recent Advances in Emulsan Production, Purification, and Application: Exploring Bioemulsifiers Unique Potentials. Int. J. Biol. Macromol. 2024, 278, 133672. [Google Scholar] [CrossRef] [PubMed]
- Ambaye, T.G.; Vaccari, M.; Prasad, S.; Rtimi, S. Preparation, Characterization and Application of Biosurfactant in Various Industries: A Critical Review on Progress, Challenges and Perspectives. Environ. Technol. Innov. 2021, 24, 102090. [Google Scholar] [CrossRef]
- Tan, Y.N.; Li, Q. Microbial Production of Rhamnolipids Using Sugars as Carbon Sources. Microb. Cell Fact. 2018, 17, 89. [Google Scholar] [CrossRef] [PubMed]
- Ghosal, D.; Ghosh, S.; Dutta, T.K.; Ahn, Y. Current State of Knowledge in Microbial Degradation of Polycyclic Aromatic Hydrocarbons (PAHs): A Review. Front. Microbiol. 2016, 7, 1369. [Google Scholar] [CrossRef]
- Eras-Muñoz, E.; Farré, A.; Sánchez, A.; Font, X.; Gea, T. Microbial Biosurfactants: A Review of Recent Environmental Applications. Bioengineered 2022, 13, 12365–12391. [Google Scholar] [CrossRef]
- Gou, X.H.; Liu, Y.Y.; Chen, Q.L.; Tang, J.J.; Liu, D.Y.; Zou, L.; Wu, X.Y.; Wang, W. High Level Expression of Bikunin in Pichia pastoris by Fusion of Human Serum Albumin. AMB Express 2012, 2, 14. [Google Scholar] [CrossRef] [PubMed]
- Kobayashi, Y.; Li, Q.; Ushimaru, K.; Hirota, M.; Morita, T.; Fukuoka, T. Updated Component Analysis Method for Naturally Occurring Sophorolipids from Starmerella bombicola. Appl. Microbiol. Biotechnol. 2024, 108, 296. [Google Scholar] [CrossRef] [PubMed]
- Sousa, M.; Dantas, I.T.; Feitosa, F.X.; Alencar, A.E.V.; Soares, S.A.; Melo, V.M.M.; Gonҫalves, L.R.B.; Sant’ana, H.B. Performance of a Biosurfactant Produced by Bacillus subtilis LAMI005 on the Formation of Oil / Biosurfactant / Water Emulsion: Study of the Phase Behaviour of Emulsified Systems. Braz. J. Chem. Eng. 2014, 31, 613–623. [Google Scholar] [CrossRef]
- Morikawa, M.; Hirata, Y.; Imanaka, T. A Study on the Structure-Function Relationship of Lipopeptide Biosurfactants. Biochim. Biophys. Acta Mol. Cell Biol. Lipids 2000, 1488, 211–218. [Google Scholar] [CrossRef] [PubMed]
- Cooper, D.G.; Goldenberg, B.G. Surface-Active Agents from Two Bacillus Species. Appl. Env. Microbiol. 1987, 53, 224–229. [Google Scholar] [CrossRef]
- Zhang, D.; Luo, L.; Jin, M.; Zhao, M.; Niu, J.; Deng, S.; Long, X. Efficient Isolation of Biosurfactant Rhamnolipids from Fermentation Broth via Aqueous Two-Phase Extraction with 2-Propanol/Ammonium Sulfate System. Biochem. Eng. J. 2022, 188, 108676. [Google Scholar] [CrossRef]
- Znamirowska, A.; Sajnar, K.; Kowalczyk, M.; Kluz, M.; Buniowska, M. Effect of Addition of Spelt and Buckwheat Hull on Selected Properties of Yoghurt. J. Microbiol. Biotechnol. Food Sci. 2020, 10, 296–300. [Google Scholar] [CrossRef]
- Wadhwa, M.; Bakshi, M.P.S. Utilization of Fruit and Vegetable Wastes as Livestock Feed and as Substrates for Generation of Other Value-Added Products; FAO: Rome, Italy, 2013; ISBN 9789251076316. [Google Scholar]
- Baumann, P. Isolation of Acinetobacter from Soil and Water. J. Bacteriol. 1968, 96, 39–42. [Google Scholar] [CrossRef]
- Ren, X.; Palmer, L.D. Acinetobacter Metabolism in Infection and Antimicrobial Resistance. Infect. Immun. 2023, 91, e0043322. [Google Scholar] [CrossRef]
- Koim-Puchowska, B.; Kłosowski, G.; Dróżdż-Afelt, J.M.; Mikulski, D.; Zielińska, A. Influence of the Medium Composition and the Culture Conditions on Surfactin Biosynthesis by a Native Bacillus subtilis Natto Bs19 Strain. Molecules 2021, 26, 2985. [Google Scholar] [CrossRef] [PubMed]
- Van Bogaert, I.N.A.; Saerens, K.; De Muynck, C.; Develter, D.; Soetaert, W.; Vandamme, E.J. Microbial Production and Application of Sophorolipids. Appl. Microbiol. Biotechnol. 2007, 76, 23–34. [Google Scholar] [CrossRef] [PubMed]
- Wongsirichot, P.; Ingham, B.; Winterburn, J. A Review of Sophorolipid Production from Alternative Feedstocks for the Development of a Localized Selection Strategy. J. Clean. Prod. 2021, 319, 128727. [Google Scholar] [CrossRef]
- Kuyukina, M.S.; Ivshina, I.B. Bioremediation of Contaminated Environments Using Rhodococcus. In Biology of Rhodococcus; Springer: Berlin/Heidelberg, Germany, 2019; pp. 231–270. [Google Scholar]
- Nazari, M.T.; Simon, V.; Machado, B.S.; Crestani, L.; Marchezi, G.; Concolato, G.; Ferrari, V.; Colla, L.M.; Piccin, J.S. Rhodococcus: A Promising Genus of Actinomycetes for the Bioremediation of Organic and Inorganic Contaminants. J. Env. Manag. 2022, 323, 116220. [Google Scholar] [CrossRef] [PubMed]
- Upadhyay, S.K.; Singh, G.; Rani, N.; Rajput, V.D.; Seth, C.S.; Dwivedi, P.; Minkina, T.; Wong, M.H.; Show, P.L.; Khoo, K.S. Transforming Bio-Waste into Value-Added Products Mediated Microbes for Enhancing Soil Health and Crop Production: Perspective Views on Circular Economy. Environ. Technol. Innov. 2024, 34, 103573. [Google Scholar] [CrossRef]
- Takada, M.; Niu, R.; Minami, E.; Saka, S. Characterization of Three Tissue Fractions in Corn (Zea mays) Cob. Biomass Bioenergy 2018, 115, 130–135. [Google Scholar] [CrossRef]
- Rahman, M.S.; Mondal, M.I.H.; Yeasmin, M.S.; Abu Sayeed, M.; Hossain, M.A.; Ahmed, M.B. Conversion of Lignocellulosic Corn Agro-Waste into Cellulose Derivative and Its Potential Application as Pharmaceutical Excipient. Processes 2020, 8, 711. [Google Scholar] [CrossRef]
- Salazar-Bryam, A.M.; Lovaglio, R.B.; Contiero, J. Biodiesel Byproduct Bioconversion to Rhamnolipids: Upstream Aspects. Heliyon 2017, 3, e00337. [Google Scholar] [CrossRef] [PubMed]
- Sleator, R.D.; Hill, C. Bacterial Osmoadaptation: The Role of Osmolytes in Bacterial Stress and Virulence. FEMS Microbiol. Rev. 2002, 26, 49–71. [Google Scholar] [CrossRef]
- Shah, M.U.H.; Sivapragasam, M.; Moniruzzaman, M.; Yusup, S.B. A Comparison of Recovery Methods of Rhamnolipids Produced by Pseudomonas aeruginosa. Procedia Eng. 2016, 148, 494–500. [Google Scholar] [CrossRef]
- Ortiz-Sanchez, M.; Inocencio-García, P.J.; Alzate-Ramírez, A.F.; Alzate, C.A.C. Potential and Restrictions of Food-Waste Valorization through Fermentation Processes. Fermentation 2023, 9, 274. [Google Scholar] [CrossRef]
- Mohanty, S.S.; Koul, Y.; Varjani, S.; Pandey, A.; Ngo, H.H.; Chang, J.S.; Wong, J.W.C.; Bui, X.T. A Critical Review on Various Feedstocks as Sustainable Substrates for Biosurfactants Production: A Way towards Cleaner Production. Microb. Cell Fact. 2021, 20, 120. [Google Scholar] [CrossRef] [PubMed]
- Effiong, E.; Agwa, O.K.; Abu, G.O. Optimization of Biosurfactant Production by a Novel Rhizobacterial Pseudomonas Species. World Sci. News 2019, 137, 18–30. [Google Scholar]
- Miller, G.L. Use of Dinitrosalicylic Acid Reagent for Determination of Reducing Sugar. Anal. Chem. 1959, 31, 426–428. [Google Scholar] [CrossRef]
- Becker, J.M.; Caldwell, G.A.; Zachgo, E.A. Protein Assays. Biotechnol.—A Lab. Course 1996, 119–124. [Google Scholar] [CrossRef]

| Genus | Species | ID | Reference Cultural Medium | Application of the Strain |
|---|---|---|---|---|
| Acinetobacter | sp. | MAD90 | BCS333 | Emulsan production |
| Bacillus | subtilis | MAD3 | BCS340 | Surfactin production |
| Rhodococcus | erythropolis | MAD02B | BCS346 BCS333 BCS342 | Bioremediation of hydrocarbons and accumulation of cesium isotopes Triacylglycerole biosynthesis Biotransformation of acrylonitrile into acrylammide PHA synthesis Hydrocarbons biotransformation |
| Candida | bombicola | MADS | BCS343 | Production of sophorolipids |
| Pseudomonas | aeruginosa | MAD10 | BCS340 | Production of rhamnolipids |
| Instrument: | Agilent Technologies 1260 Infinity |
|---|---|
| Column | Aminex HPX-87H (BioRad) 300 × 7.8 mm |
| Mobile Phase | 5 mM sulfuric acid |
| Flux | 0.6 mL min−1 |
| Gradient | isocratic |
| Injection volume | 10 µL |
| Temperature | 30 °C |
| Detector | Refractive Index Detector (RID) |
| Run Time | 30 min |
| Column: | Hypersil ODS 250 × 4.6 mm, 5 µm | ||
|---|---|---|---|
| Mobile phase A | 10 mM ammonium acetate (MeCOONH4) pH 7.4 | ||
| Mobile phase B | Acetonitrile (MeCN): 10 mM ammonium acetate (MeCOONH4) pH 7.4 = 80:20 | ||
| Flow | 0.5 mL min−1 | ||
| Injection Volume | 20 µL | ||
| Detector | UV (λ = 230 nm) | ||
| MS | 4000 V, negative, 200/1000 m z−1, frag:VAR | ||
| Temperature: | 25 °C | ||
| Gradient: | Time (min) | Mobile phase A (%) | Mobile phases B (%) |
| 0 | 70 | 30 | |
| 50 | 10 | 90 | |
| 55 | 10 | 90 | |
| 56 | 70 | 30 | |
| 66 | 70 | 30 | |
| Stop time | 66 min | ||
| Column | LiCrosphere RP18 (150 × 4.6 mm, 5 µm) |
|---|---|
| Mobile Phase | Water:acetonitrile:trifluoroacetic acid 20:80:0.025% |
| Flow | 1 mL min−1 |
| Gradient | Isocratic |
| Injection volume | 10 µL |
| Temperature | 25 °C |
| Detector | UV (λ = 205 nm) |
| Run Time | 25 min |
| Strain | ID | Oat and Emmer Chaff | Corn Chaff | Proteic Pea Pod Hull | Control | Biosurfactant Produced in Control Conditions | ||||
|---|---|---|---|---|---|---|---|---|---|---|
| Acinetobacter sp. | MAD90 | 1.1 × 1010 | − | 9.0 × 109 | − | 5.0 × 109 | − | 9.0 × 109 | + | Emulsan |
| Bacillus subtilis | MAD3 | 3.7 × 109 | + | 1.3 × 109 | + | 7.6 × 109 | + | 5.5 × 109 | + | Surfactin |
| Candida bombicola | NA | 1.0 × 109 | − | 2.7 ×109 | − | 3.8 × 108 | − | 7.5 × 107 | + | Sophorolipids |
| Pseudomonas aeruginosa | MAD10 | 4.3 × 109 | − | 2.7 × 1010 | + | 2.2 × 1010 | − | 7.0 × 109 | + | Rhamnolipids |
| Rhodococcus erythropolis | MADO2B | 1.4 × 109 | − | 1.7 × 109 | − | 4.3 × 109 | − | 5.0 × 109 | + | Trehalolipids |
| Trial ID# | Components of the Fermentation Medium | Amount for Each Component (g L−1) | Maximum Rhamnolipids Production Achieved (g L−1) |
|---|---|---|---|
| A | Corn Chaff | 100 | 11.8 |
| Glycerol | 40 | ||
| NaNO3 | 2 | ||
| KH2PO4 | 1 | ||
| B | Corn Chaff | 100 | 9.4 |
| Glycerol | 40 | ||
| KH2PO4 | 1 | ||
| C | Corn Chaff | 100 | 17.9 |
| Glycerol | 40 | ||
| Soybean Oil | 20 | ||
| NaNO3 | 2 | ||
| KH2PO4 | 1 | ||
| D | Corn Chaff | 100 | 16.4 |
| Glycerol | 40 | ||
| WCO | 20 | ||
| NaNO3 | 2 | ||
| KH2PO4 | 1 | ||
| E | Corn Chaff | 100 | 11.1 |
| Glycerol | 60 | ||
| NaNO3 | 2 | ||
| KH2PO4 | 1 | ||
| F | Corn Chaff | 100 | 8.1 |
| Soybean Oil | 20 | ||
| NaNO3 | 2 | ||
| KH2PO4 | 1 | ||
| G * | Glycerol | 40 | 0.0 *** |
| NaNO3 | 2 | ||
| KH2PO4 | 1 | ||
| H | Corn Chaff | 100 | <2.0 ** |
| NaNO3 | 2 | ||
| KH2PO4 | 1 | ||
| I * | Soybean Oil | 20 | 0.0 *** |
| NaNO3 | 2 | ||
| KH2PO4 | 1 | ||
| J | Oat and Emmer Hull | 50 | <2.0 ** |
| Corn Chaff | 50 | ||
| K * | Oat and Emmer Hull | 50 | 0.0 *** |
| Pea pod hull | 50 | ||
| L | Corn Chaff | 100 | <2.0 ** |
| M | Corn Chaff | 100 | 8.6 |
| Soybean Oil | 20 | ||
| N | Corn Chaff | 100 | 6.1 |
| WCO | 20 | ||
| O | BCS340 (positive control, Industrial Medium) | 15.0 | |
| Glucose | 20 | ||
| Glycerol | 40 | ||
| Soybean oil | 20 | ||
| Soybean meal | 20 |
| Sample | pH | Concentration | Yield |
|---|---|---|---|
| g L−1 | % | ||
| Total culture broth (1) | 6.2 | 12.5 | 100 |
| Filtered supernatant (2) | 6.2 | 92 | |
| Organic extract (3) | 63.4 |
| Rt (min) | Compound | Structure | Area % |
|---|---|---|---|
| 24.13 | Rha-Rha-C8-C10 Rha-Rha-C10-C8 | ![]() | 13.44 |
| 27.53 | Rha-Rha-C10-C10 | ![]() | 66.87 |
| 30.26 | Rha-C10-C10 | ![]() | 4.18 |
| 30.82 | Rha-Rha C10-C12:1 | ![]() | 13.1 |
| 31.67 | Rha-Rha-C12:1-C10 | ![]() | <1.5 |
| 3.78 | Rha-Rha-C10-C12 Rha-Rha-C12-C10 | ![]() | <1.5 |
| RL Tot considered | 97.59 |
Disclaimer/Publisher’s Note: The statements, opinions and data contained in all publications are solely those of the individual author(s) and contributor(s) and not of MDPI and/or the editor(s). MDPI and/or the editor(s) disclaim responsibility for any injury to people or property resulting from any ideas, methods, instructions or products referred to in the content. |
© 2025 by the authors. Licensee MDPI, Basel, Switzerland. This article is an open access article distributed under the terms and conditions of the Creative Commons Attribution (CC BY) license (https://creativecommons.org/licenses/by/4.0/).
Share and Cite
Bava, A.; Carnelli, S.; Vaccari, M.; Beffa, T.; Beltrametti, F. Identification of Corn Chaff as an Optimal Substrate for the Production of Rhamnolipids in Pseudomonas aeruginosa Fermentations. Fermentation 2025, 11, 74. https://doi.org/10.3390/fermentation11020074
Bava A, Carnelli S, Vaccari M, Beffa T, Beltrametti F. Identification of Corn Chaff as an Optimal Substrate for the Production of Rhamnolipids in Pseudomonas aeruginosa Fermentations. Fermentation. 2025; 11(2):74. https://doi.org/10.3390/fermentation11020074
Chicago/Turabian StyleBava, Adriana, Sara Carnelli, Mentore Vaccari, Trello Beffa, and Fabrizio Beltrametti. 2025. "Identification of Corn Chaff as an Optimal Substrate for the Production of Rhamnolipids in Pseudomonas aeruginosa Fermentations" Fermentation 11, no. 2: 74. https://doi.org/10.3390/fermentation11020074
APA StyleBava, A., Carnelli, S., Vaccari, M., Beffa, T., & Beltrametti, F. (2025). Identification of Corn Chaff as an Optimal Substrate for the Production of Rhamnolipids in Pseudomonas aeruginosa Fermentations. Fermentation, 11(2), 74. https://doi.org/10.3390/fermentation11020074







